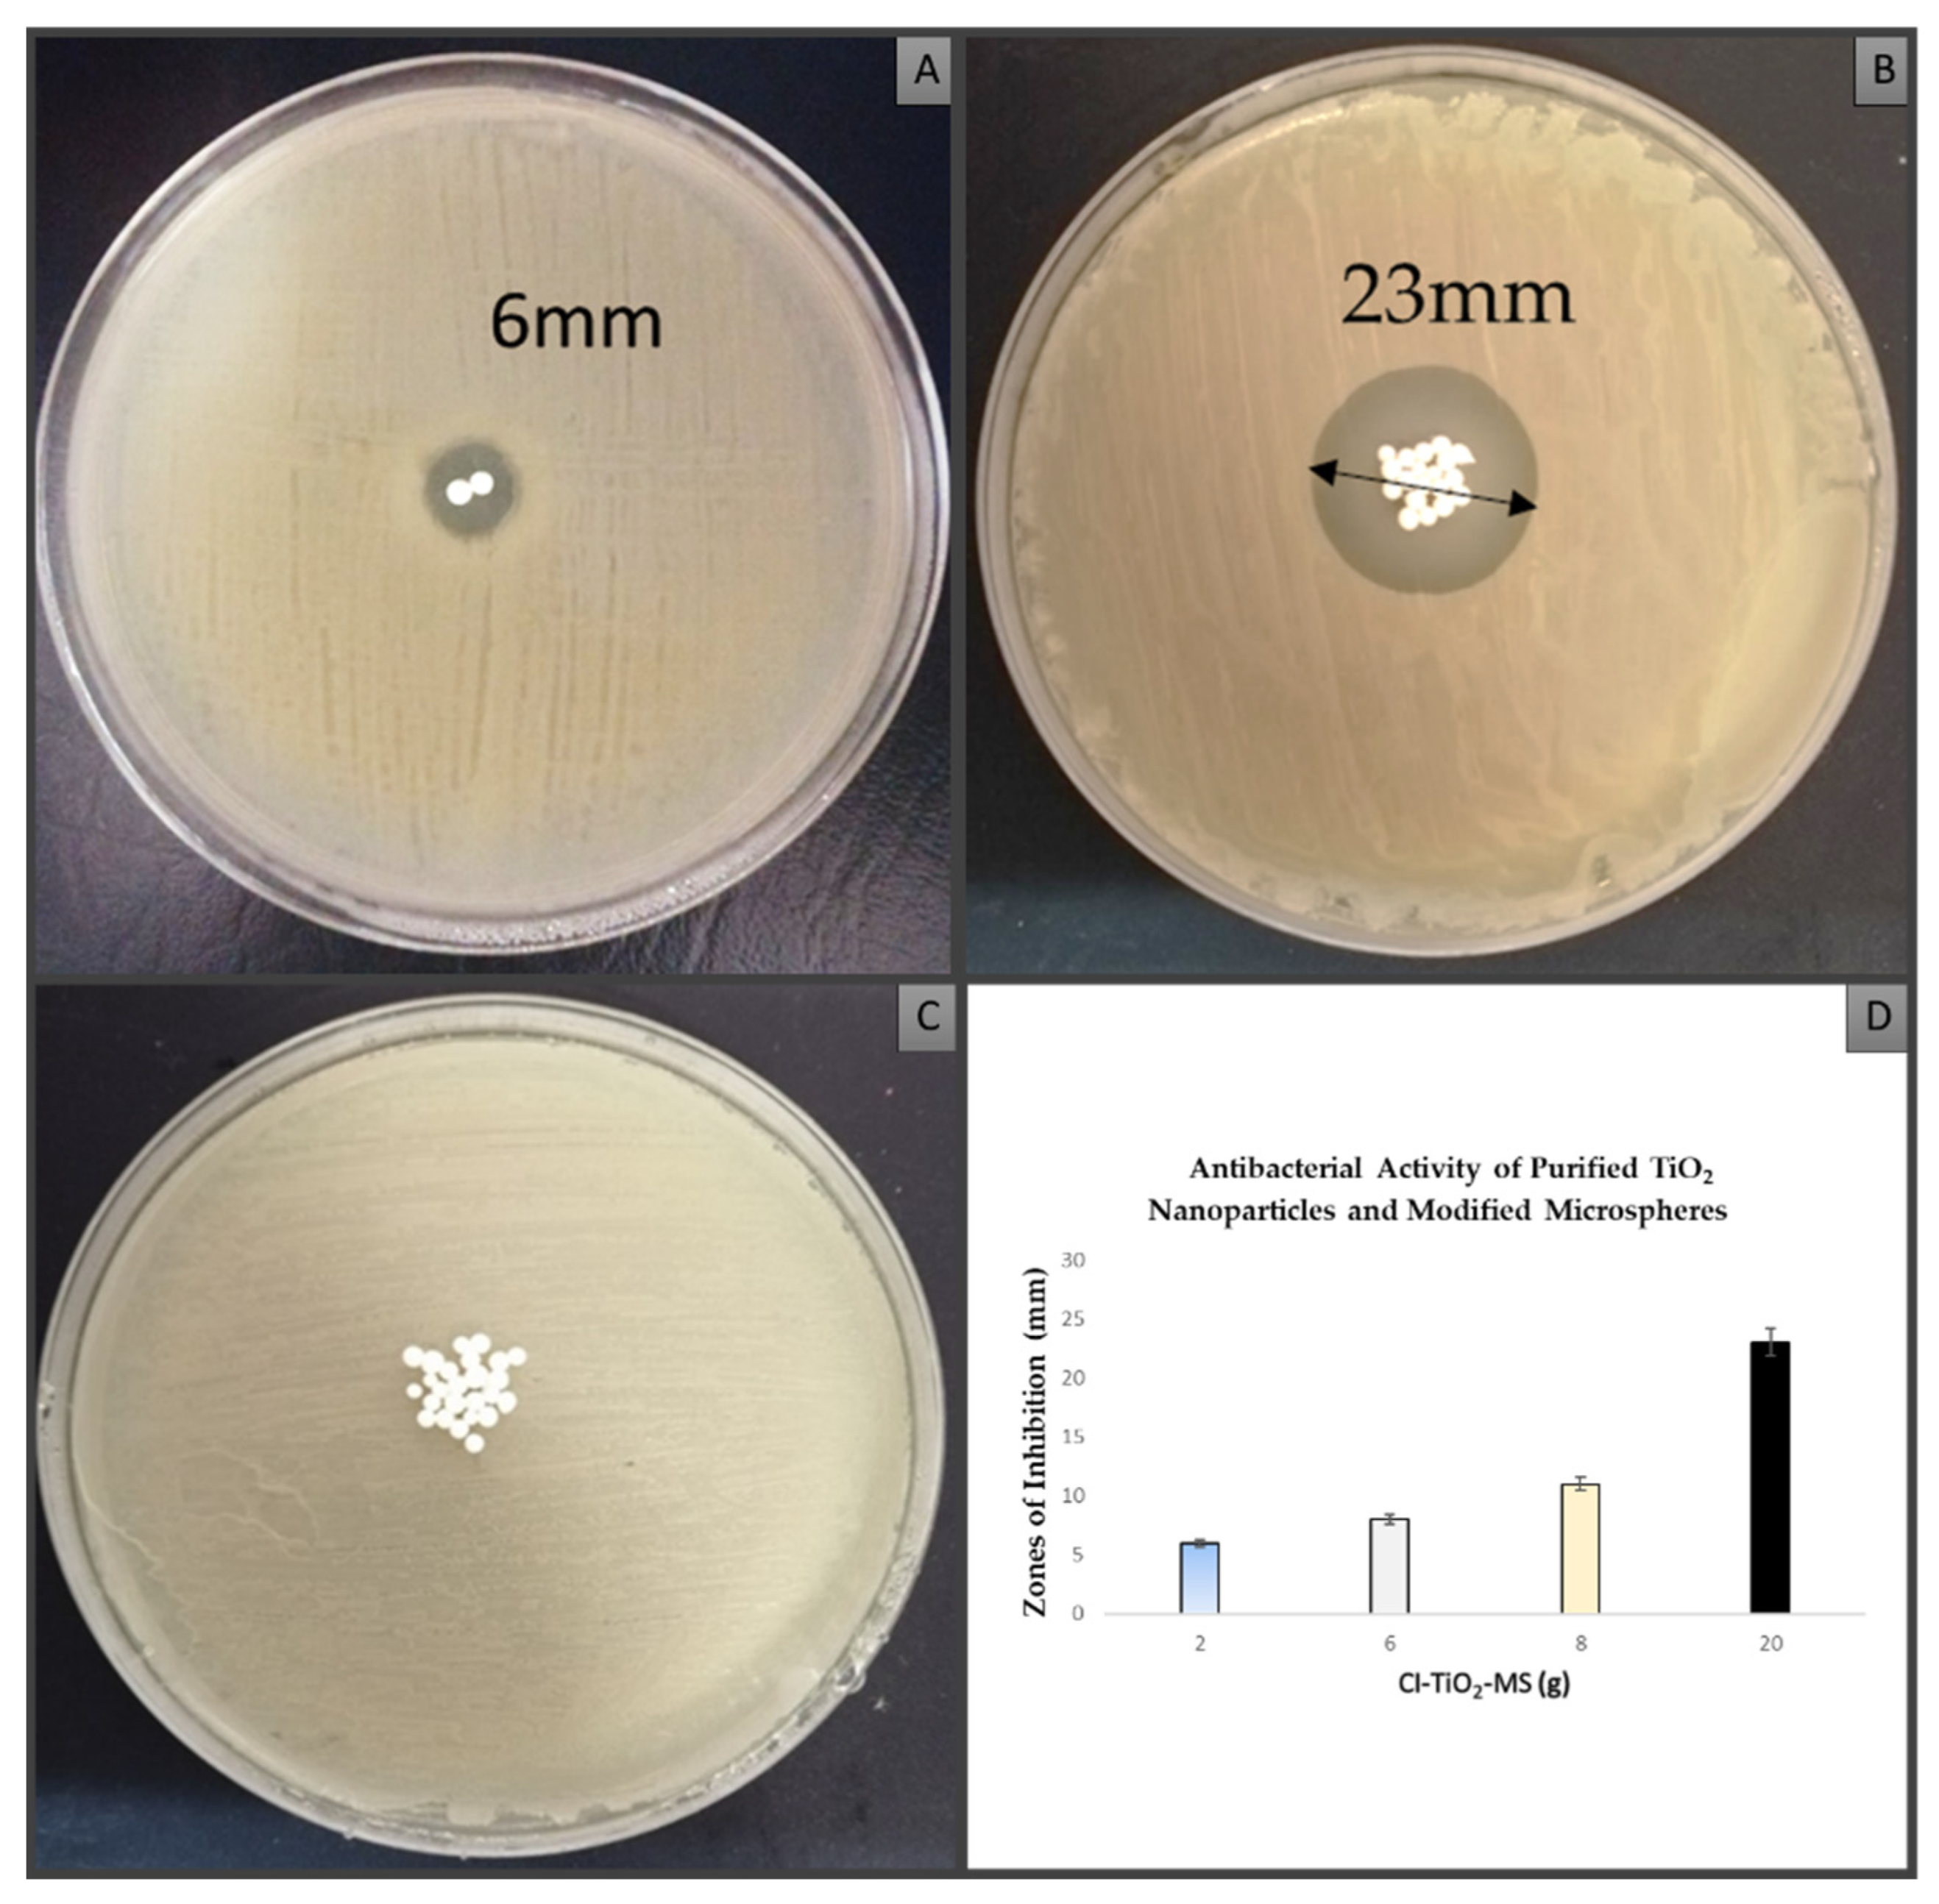
Pharmaceutics 14 02764 g010 Pharmaceutics 14 02764 g010

Synthesis and Characterization of Calcium Alginate-Based Microspheres Entrapped with TiO2 Nanoparticles and Cinnamon Essential Oil Targeting Clinical Staphylococcus aureus
Abstract
1. Introduction
2. Materials and Methods
2.1. Bacterial Strains
2.2. Antibiotic Susceptibility Testing
2.3. Screening of Essential Oils for Synthesis of Modified Microspheres
2.4. Biosynthesis of TiO2 Nanoparticles Using Extract of Nigella sativa Seed
2.4.1. Preparation of Extract of Nigella sativa Seed
2.4.2. GCMS of Nigella sativa Seed Extract
2.4.3. Biosynthesis of TiO2 Nanoparticles
2.5. Synthesis of Calcium Alginate-Based Microspheres
- (a)
- Preparation of CaCl2 solution: A CaCl2 solution was prepared by dissolving 1.4 g of CaCl2 (Oxoid Ltd.) in 20 mL of sterile distilled water. The obtained solution was kept for 10 min at room temperature.
- (b)
- Incorporation of TiO2 nanoparticles and essential oil in calcium alginate: A total of 0.4 g of sodium alginate (Oxoid Ltd.) was dissolved in 10 mL of double-distilled water and stirred for about 10 min. Then, 0.2 g of the TiO2 nanoparticles and 1.5 mL of the selected essential oil (i.e., the cinnamon essential oil) were added separately in a dropwise manner.
- (c)
- Formation of microspheres by ionotropic gelation method: The prepared TiO2 nanoparticles and cinnamon essential oil with calcium alginate incorporated was drawn up in a 5 mL syringe with a 22-gauge needle and added dropwise to a CaCl2 solution. The synthesized microspheres were kept in a CaCl2 solution for about 10 min.
- (d)
- Drying of microspheres: The microspheres were rinsed with distilled water and desiccated in a drying oven for 24 h at 45 °C. The synthesized microspheres were stored at 4 °C in microcentrifuge tubes for further use.
2.6. Characterization of Purified TiO2 Nanoparticles and Modified Microspheres
2.7. Antibacterial Activity of Modified Microspheres
2.8. Detection of Membrane-Damaging Potential by Flow Cytometry
2.9. Observation of Morphological Changes in Staphylococcus aureus Cells
2.10. Biofilm Inhibition Analysis
2.11. Hemolytic Activity Analysis
2.12. Statistics
3. Results
3.1. Antibiotic Susceptibility Testing
3.2. Screening of Essential Oils for Modified Microspheres
3.3. GCMS of Extract of Nigella sativa Seed
3.4. Characterization of Purified TiO2 Nanoparticles and Modified Microspheres
3.5. Antibacterial Activity of Purified TiO2 Nanoparticles and Modified Microspheres
3.6. Detection of Cell Membrane Damage by Flow Cytometry
3.7. Observation of Morphological Changes in Cells of Staphylococcus aureus
3.8. Biofilm Inhibition Analysis
3.9. Hemolytic Activity Analysis
4. Discussion
Proposed Mechanism of Action of Modified Microspheres
5. Conclusions
Author Contributions
Funding
Institutional Review Board Statement
Informed Consent Statement
Data Availability Statement
Acknowledgments
Conflicts of Interest
Abbreviations
| AHL | Acyl homoserine lactone |
| ATP | Adenosine triphosphate |
| ATPase | adenosine triphosphatase |
| CaCl2 | Calcium chloride |
| CI | Cinnamon essential oil |
| CI-TiO2-MS | Microspheres loaded with cinnamon essential oil and TiO2 nanoparticles |
| CLSI | Clinical and Laboratory Standards Institute |
| DMSO | Dimethylsulfoxide |
| DNA | Deoxyribonucleic acid |
| EDX | Energy dispersive X-ray |
| FITC | fluorescein isothiocyante |
| FTIR | Fourier transform infrared |
| FtsZ | Filamenting temperature-sensitive mutant Z |
| GCMS | Gas Chromatography Mass Spectrometry |
| MDR | Multi-drug resistant |
| MS | Blank microsphere |
| PBS | Phosphate buffer saline |
| ROS | Reactive oxygen species |
| SEM | Scanning electron microscopy |
| TiO2-MS | Microspheres loaded with TiO2 nanoparticles |
| XRD | X-ray Diffraction |
References
- Mi, G.; Shi, D.; Wang, M.; Webster, T.J. Reducing bacterial infections and biofilm formation using nanoparticles and nanostructured antibacterial surfaces. Adv. Healthc. Mater. 2018, 7, 1800103. [Google Scholar] [CrossRef] [PubMed]
- Lewis, K. Platforms for antibiotic discovery. Nat. Rev. Drug Discov. 2013, 12, 371–387. [Google Scholar] [CrossRef] [PubMed]
- Mancuso, G.; Midiri, A.; Gerace, E.; Biondo, C. Bacterial Antibiotic Resistance: The Most Critical Pathogens. Pathogens 2021, 10, 1310. [Google Scholar] [CrossRef] [PubMed]
- Davies, J.; Davies, D. Origins and Evolution of Antibiotic Resistance. Microbiol. Mol. Biol. Rev. 2010, 74, 417–433. [Google Scholar] [CrossRef]
- Blair, J.M.A.; Webber, M.A.; Baylay, A.J.; Ogbolu, D.O.; Piddock, L.J.V. Molecular mechanisms of antibiotic resistance. Nat. Rev. Microbiol. 2015, 13, 42–51. [Google Scholar] [CrossRef]
- Alekshun, M.N.; Levy, S.B. Molecular Mechanisms of Antibacterial Multidrug Resistance. Cell 2007, 128, 1037–1050. [Google Scholar] [CrossRef]
- Centers for Disease Control and Prevention [CDC]. Antibiotic/Antimicrobial Resistance: Antibiotic Resistance Threats in the United States; United States Department of Health and Human Services: Washington, DC, USA, 2013.
- Wang, L.; Hu, C.; Shao, L. The antimicrobial activity of nanoparticles: Present situation and prospects for the future. Int. J. Nanomed. 2017, 12, 1227–1249. [Google Scholar] [CrossRef] [PubMed]
- Dizaj, S.M.; Lotfipour, F.; Barzegar-Jalali, M.; Zarrintan, M.H.; Adibkia, K. Antimicrobial activity of the metals and metal oxide nanoparticles. Mater. Sci. Eng. C 2014, 44, 278–284. [Google Scholar] [CrossRef]
- Tepe, B.; Daferera, D.; Sökmen, M.; Polissiou, M.; Sökmen, A. In vitro antimicrobial and antioxidant activities of the essential oils and various extracts of Thymus eigii M. Zohary et PH Davis. J. Agric. Food Chem. 2004, 52, 1132–1137. [Google Scholar] [CrossRef]
- Amin, R.; Hwang, S.; Park, S.H. Nanobiotechnology: An interface between nanotechnology and biotechnology. Nano 2011, 6, 101–111. [Google Scholar] [CrossRef]
- Zallen, R.; Moret, M. The optical absorption edge of brookite TiO2. Solid State Commun. 2006, 137, 154–157. [Google Scholar] [CrossRef]
- Shi, H.; Magaye, R.; Castranova, V.; Zhao, J. Titanium dioxide nanoparticles: A review of current toxicological data. Part. Fibre Toxicol. 2013, 10, 15. [Google Scholar] [CrossRef] [PubMed]
- Ziental, D.; Czarczynska-Goslinska, B.; Mlynarczyk, D.T.; Glowacka-Sobotta, A.; Stanisz, B.; Goslinski, T.; Sobotta, L. Titanium Dioxide Nanoparticles: Prospects and Applications in Medicine. Nanomaterials 2020, 10, 387. [Google Scholar] [CrossRef]
- Burt, S. Essential oils: Their antibacterial properties and potential applications in foods—A review. Int. J. Food Microbiol. 2004, 94, 223–253. [Google Scholar] [CrossRef]
- Kordali, S.; Kotan, R.; Mavi, A.; Cakir, A.; Ala, A.; Yildirim, A. Determination of the chemical composition and antioxidant activity of the essential oil of Artemisia dracunculus and of the antifungal and antibacterial activities of Turkish Artemisia absinthium, A. dracunculus, Artemisia santonicum, and Artemisia spicigera essential oils. J. Agric. Food Chem. 2005, 53, 9452–9458. [Google Scholar]
- Faidi, A.; Lassoued, M.A.; Becheikh, M.E.H.; Touati, M.; Stumbé, J.-F.; Farhat, F. Application of sodium alginate extracted from a Tunisian brown algae Padina pavonica for essential oil encapsulation: Microspheres preparation, characterization and in vitro release study. Int. J. Biol. Macromol. 2019, 136, 386–394. [Google Scholar] [CrossRef]
- Sahil, K.; Akanksha, M.; Premjeet, S.; Bilandi, A.; Kapoor, B. Microsphere: A review. Int. J. Res. Pharm. Chem. 2011, 1, 1184–1198. [Google Scholar]
- Abourehab, M.A.S.; Rajendran, R.R.; Singh, A.; Pramanik, S.; Shrivastav, P.; Ansari, M.J.; Manne, R.; Amaral, L.S.; Deepak, A. Alginate as a Promising Biopolymer in Drug Delivery and Wound Healing: A Review of the State-of-the-Art. Int. J. Mol. Sci. 2022, 23, 9035. [Google Scholar] [CrossRef]
- Rajaonarivony, M.; Vauthier, C.; Couarraze, G.; Puisieux, F.; Couvreur, P. Development of a New Drug Carrier Made from Alginate. J. Pharm. Sci. 1993, 82, 912–917. [Google Scholar] [CrossRef]
- Wang, H.; Deng, H.; Gao, M.; Zhang, W. Self-Assembled Nanogels Based on Ionic Gelation of Natural Polysaccharides for Drug Delivery. Front. Bioeng. Biotechnol. 2021, 9, 703559. [Google Scholar] [CrossRef] [PubMed]
- Reller, L.B.; Weinstein, M.; Jorgensen, J.H.; Ferraro, M. Antimicrobial susceptibility testing: A review of general principles and contemporary practices. Clin. Infect. Dis. 2009, 49, 1749–1755. [Google Scholar]
- Jorgensen, J.H.; Turnidge, J.D. Susceptibility Test Methods: Dilution and Disk Diffusion Methods. In Manual of Clinical Microbiology, 11th ed.; Jorgensen, J., Pfaller, M., Carroll, K., Funke, G., Landry, M., Richter, S., Warnock, D., Eds.; ASM Press: Washington, DC, USA, 2015; Chapter 71; pp. 1253–1273. [Google Scholar]
- Magaldi, S.; Mata-Essayag, S.; De Capriles, C.H.; Perez, C.; Colella, M.T.; Olaizola, C.; Ontiveros, Y. Well diffusion for antifungal susceptibility testing. Int. J. Infect. Dis. 2004, 8, 39–45. [Google Scholar] [CrossRef] [PubMed]
- Srinivasan, K.; Sivasubramanian, S.; Kumaravel, S. Phytochemical profiling and GC-MS study of Adhatoda vasica leaves. Int. J. Pharm. Biol. Sci. 2013, 5, 714–720. [Google Scholar]
- Nivetha, K.; Prasanna, G. GC-MS and FT-IR analysis of Nigella sativa L. seeds. Int. J. Adv. Res. Biol. Sci. 2016, 3, 45–54. [Google Scholar]
- Anbalagan, K.; Mohanraj, S.; Pugalenthi, V. Rapid phytosynthesis of nano-sized titanium using leaf extract of Azadirachta indica. Int. J. Chem. Techol. Res. 2015, 8, 2047–2052. [Google Scholar]
- Albarelli, J.Q.; Santos, D.T.; Murphy, S.; Oelgemöller, M. Use of Ca–alginate as a novel support for TiO2 immobilization in methylene blue decolorisation. Water Sci. Technol. 2009, 60, 1081–1087. [Google Scholar] [CrossRef]
- Iqbal, H.; Razzaq, A.; Uzair, B.; Ain, N.U.; Sajjad, S.; Althobaiti, N.A.; Albalawi, A.E.; Menaa, B.; Haroon, M.; Khan, M.; et al. Breast Cancer Inhibition by Biosynthesized Titanium Dioxide Nanoparticles Is Comparable to Free Doxorubicin but Appeared Safer in BALB/c Mice. Materials 2021, 14, 3155. [Google Scholar] [CrossRef]
- Venkatesan, J.; Lee, J.-Y.; Kang, D.S.; Anil, S.; Kim, S.-K.; Shim, M.S.; Kim, D.G. Antimicrobial and anticancer activities of porous chitosan-alginate biosynthesized silver nanoparticles. Int. J. Biol. Macromol. 2017, 98, 515–525. [Google Scholar] [CrossRef] [PubMed]
- Larosa, C.; Salerno, M.; de Lima, J.S.; Meri, R.M.; da Silva, M.F.; de Carvalho, L.B.; Converti, A. Characterisation of bare and tannase-loaded calcium alginate beads by microscopic, thermogravimetric, FTIR and XRD analyses. Int J. Biol Macromol. 2018, 115, 900–906. [Google Scholar] [CrossRef]
- Ozseker, E.E.; Akkaya, A. Development of a new antibacterial biomaterial by tetracycline immobilization on calcium-alginate beads. Carbohydr. Polym. 2016, 151, 441–451. [Google Scholar] [CrossRef]
- Abid, S.; Uzair, B.; Niazi, M.B.K.; Fasim, F.; Bano, S.A.; Jamil, N.; Batool, R.; Sajjad, S. Bursting the Virulence Traits of MDR Strain of Candida albicans Using Sodium Alginate-based Microspheres Containing Nystatin-loaded MgO/CuO Nanocomposites. Int. J. Nanomed. 2021, 16, 1157–1174. [Google Scholar] [CrossRef]
- Zhu, W.; Yang, G.; Zhang, Y.; Yuan, J.; An, L. Generation of Biotechnology-Derived Flavobacterium columnare Ghosts by PhiX174 Gene E-Mediated Inactivation and the Potential as Vaccine Candidates against Infection in Grass Carp. J. Biomed. Biotechnol. 2012, 2012, 760730. [Google Scholar] [CrossRef] [PubMed]
- Wijesinghe, G.K.; Feiria, S.B.; Maia, F.C.; Oliveira, T.R.; Joia, F.; Barbosa, J.P.; Boni, G.C.; Höfling, J.F. In-vitro Antibacterial and Antibiofilm Activity of Cinnamomum verum Leaf Oil against Pseudomonas aeruginosa, Staphylococcus aureus and Klebsiella pneumoniae. An. Acad. Bras. Cienc. 2021, 93, e20201507. [Google Scholar] [CrossRef] [PubMed]
- Buxton, R. Blood Agar Plates and Hemolysis Protocols. American Society for Microbiology. 2005. Available online: https://www.asm.org/getattachment/7ec0de2b-bb16-4f6e-ba07-2aea25a43e76/protocol-2885.pdf (accessed on 20 November 2019).
- Hema, M.; Arasi, A.; Tamilselvi, P.; Anbarasan, R. Titania Nanoparticles Synthesized by Sol-Gel Technique. Chem. Sci. Trans. 2013, 2, 239–245. [Google Scholar] [CrossRef]
- Hosseini, S.M.; Hosseini, H.; Mohammadifar, M.A.; Mortazavian, A.M.; Mohammadi, A.; Khosravi-Darani, K.; Shojaee-Alibadi, S.; Dehghan, S.; Khaksar, R. Incorporation of essential oil in alginate microparticles by multiple emulsion/ionic gelation process. Int. J. Biol. Macromol. 2013, 62, 582–588. [Google Scholar] [CrossRef]
- Mateus, A.Y.P.; Barrias, C.C.; Ribeiro, C.; Ferraz, M.P.; Monteiro, F.J. Comparative study of nanohydroxyapatite microspheres for medical applications. J. Biomed. Mater. Res. Part A 2008, 86, 483–493. [Google Scholar] [CrossRef]
- Fang, D.; Liu, Y.; Jiang, S.; Nie, J.; Ma, G. Effect of intermolecular interaction on electrospinning of sodium alginate. Carbohydr. Polym. 2011, 85, 276279. [Google Scholar] [CrossRef]
- Fabia, J.; Slusarczyk, C.Z.; Gawlowski, A.; Graczyk, T.; Wlochowicz, A.; Janicki, J. Supermolecular structure of alginate fibres for medical aplications studied by means of WAXS and SAXS methods. Fibres Text. East. Eur. 2005, 13, 53. [Google Scholar]
- Haque, F.Z.; Nandanwar, R.; Singh, P. Evaluating photodegradation properties of anatase and rutile TiO2 nanoparticles for organic compounds. Optik 2017, 128, 191–200. [Google Scholar] [CrossRef]
- León, A.; Reuquen, P.; Garín, C.; Segura, R.; Vargas, P.; Zapata, P.; Orihuela, P.A. FTIR and Raman Characterization of TiO2 Nanoparticles Coated with Polyethylene Glycol as Carrier for 2-Methoxyestradiol. Appl. Sci. 2017, 7, 49. [Google Scholar] [CrossRef]
- Adzmi, F.; Meon, S.; Musa, M.H.; Yusuf, N.A. Preparation, characterisation and viability of encapsulated Trichoderma harzianum UPM40 in alginate-montmorillonite clay. J. Microencapsul. 2012, 29, 205–210. [Google Scholar] [CrossRef] [PubMed]
- Munhuweyi, K.; Caleb, O.J.; van Reenen, A.J.; Opara, U.L. Physical and antifungal properties of β-cyclodextrin microcapsules and nanofibre films containing cinnamon and oregano essential oils. LWT Food Sci. Technol. 2018, 87, 413–422. [Google Scholar] [CrossRef]
- Wu, Y.W.; Sun, S.Q.; Zhou, Q.; Tao, J.X.; Noda, I. Volatility-dependent 2D IR correlation analysis of traditional Chinese medicine ‘Red Flower Oil’ preparation from different manufacturers. J. Mol. Struct. 2008, 882, 107–115. [Google Scholar] [CrossRef]
- El-Kamel, A.H.; Al-Gohary, O.M.N.; Hosny, E.A. Alginate-diltiazem hydrochloride beads: Optimization of formulation factors, in vitro and in vivo availability. J. Microencapsul. 2003, 20, 211–225. [Google Scholar] [CrossRef]
- Dayem, A.A.; Hossain, M.K.; Lee, S.B.; Kim, K.; Saha, S.K.; Yang, G.-M.; Choi, H.Y.; Cho, S.-G. The Role of Reactive Oxygen Species (ROS) in the Biological Activities of Metallic Nanoparticles. Int. J. Mol. Sci. 2017, 18, 120. [Google Scholar] [CrossRef]
- Nazzaro, F.; Fratianni, F.; De Martino, L.; Coppola, R.; De Feo, V. Effect of essential oils on pathogenic bacteria. Pharmaceuticals 2013, 6, 1451–1474. [Google Scholar] [CrossRef]
- Lambert, R.; Skandamis, P.; Coote, P.; Nychas, G.-J. A study of the minimum inhibitory concentration and mode of action of oregano essential oil, thymol and carvacrol. J. Appl. Microbiol. 2001, 91, 453–462. [Google Scholar] [CrossRef]
- Domadia, P.; Swarup, S.; Bhunia, A.; Sivaraman, J.; Dasgupta, D. Inhibition of bacterial cell division protein FtsZ by cinnamaldehyde. Biochem. Pharmacol. 2007, 74, 831–840. [Google Scholar] [CrossRef]
- Thoroski, J.; Blank, G.; Biliaderis, C. Eugenol Induced Inhibition of Extracellular Enzyme Production by Bacillus subtilis. J. Food Prot. 1989, 52, 399–403. [Google Scholar] [CrossRef]
- Usta, J.; Kreydiyyeh, S.; Barnabe, P.; Bou-Moughlabay, Y.; Nakkash-Chmaisse, H. Comparative study on the effect of cinnamon and clove extracts and their main components on different types of ATPases. Hum. Exp. Toxicol. 2003, 22, 355–362. [Google Scholar]
- Oussalah, M.; Caillet, S.; Saucier, L.; Lacroix, M. Antimicrobial effects of selected plant essential oils on the growth of a Pseudomonas putida strain isolated from meat. Meat Sci. 2006, 73, 236–244. [Google Scholar] [CrossRef]
- Hyldgaard, M.; Mygind, T.; Meyer, R.L. Essential Oils in Food Preservation: Mode of Action, Synergies, and Interactions with Food Matrix Components. Front. Microbiol. 2012, 3, 12. [Google Scholar] [CrossRef]
- Khan, M.; Zahin, M.; Hasan, S.; Husain, F.; Ahmad, I. Inhibition of quorum sensing regulated bacterial functions by plant essential oils with special reference to clove oil. Lett. Appl. Microbiol. 2009, 49, 354–360. [Google Scholar] [CrossRef] [PubMed]
- Doyle, A.A.; Stephens, J.C. A review of cinnamaldehyde and its derivatives as antibacterial agents. Fitoterapia 2019, 139, 104405. [Google Scholar] [CrossRef] [PubMed]
- Kim, Y.J.; Park, H.G.; Yang, Y.L.; Yoon, Y.; Kim, S.; Oh, E. Multifunctional Drug Delivery System Using Starch-Alginate Beads for Controlled Release. Biol. Pharm. Bull. 2005, 28, 394–397. [Google Scholar] [CrossRef]
- Taqieddin, E.; Amiji, M. Enzyme immobilization in novel alginate–chitosan core-shell microcapsules. Biomaterials 2004, 25, 1937–1945. [Google Scholar] [CrossRef] [PubMed]
- Ribeiro, C.; Barrias, C.; Barbosa, M. Calcium phosphate-alginate microspheres as enzyme delivery matrices. Biomaterials 2004, 25, 4363–4373. [Google Scholar] [CrossRef]
- Mittal, R.P.; Rana, A.; Jaitak, V. Essential oils: An impending substitute of synthetic antimicrobial agents to overcome antimicrobial resistance. Curr. Drug Targets 2019, 20, 605–624. [Google Scholar] [CrossRef]
- Barrias, C.C.; Ribeiro, C.C.; Barbosa, M.A. Adhesion and proliferation of human osteoblastic cells seeded on injectable hydroxyapatite microspheres. Key Eng. Mater. 2004, 254, 877–880. [Google Scholar]
- Ribeiro, C.C.; Barrias, C.; Barbosa, M. Preparation and characterisation of calcium-phosphate porous microspheres with a uniform size for biomedical applications. J. Mater. Sci. Mater. Med. 2006, 17, 455–463. [Google Scholar] [CrossRef]
- Liu, X.D.; Yu, W.Y.; Zhang, Y.; Xue, W.M.; Xiong, Y.; Ma, X.J.; Chen, Y.; Yuan, Q. Characterization of structure and diffusion behaviour of Ca-alginate beads prepared with external or internal calcium sources. J. Microencapsul. 2002, 19, 775–782. [Google Scholar] [CrossRef] [PubMed]
- Legallais, C.; David, B.; Doré, E. Bioartificial livers (BAL): Current technological aspects and future developments. J. Membr. Sci. 2001, 181, 81–95. [Google Scholar] [CrossRef]
- Barbosa, M.; Granja, P.; Barrias, C.; Amaral, I. Polysaccharides as scaffolds for bone regeneration. ITBM-RBM 2005, 26, 212–217. [Google Scholar] [CrossRef]
- Hari, P.R.; Chandy, T.; Sharma, C.P. Chitosan/calcium—Alginate beads for oral delivery of insulin. J. Appl. Polym. Sci. 1996, 59, 1795–1801. [Google Scholar] [CrossRef]
- Kong, H.J.; Smith, M.K.; Mooney, D.J. Designing alginate hydrogels to maintain viability of immobilized cells. Biomaterials 2003, 24, 4023–4029. [Google Scholar] [CrossRef]
- Youssef, Z.; Vanderesse, R.; Colombeau, L.; Baros, F.; Roques-Carmes, T.; Frochot, C.; Wahab, H.; Toufaily, J.; Hamieh, T.; Acherar, S.; et al. The application of titanium dioxide, zinc oxide, fullerene, and graphene nanoparticles in photodynamic therapy. Cancer Nanotechnol. 2017, 8, 6. [Google Scholar] [CrossRef]
- Siegrist, S.; Cörek, E.; Detampel, P.; Sandström, J.; Wick, P.; Huwyler, J. Preclinical hazard evaluation strategy for nanomedicines. Nanotoxicology 2019, 13, 73–99. [Google Scholar] [CrossRef]

| Wave Number (cm−1) | Vibration Mode | References |
|---|---|---|
| 480–521 | Ti-O-Ti bending vibration | [42] |
| 664 | Ti-O-Ti bending vibration | [42] |
| 1631 | OH mode bending mode of water Ti-OH | [43] |
| 1595 | Asymmetric stretching vibrations of free carboxyl groups | [44] |
| 325 | OH stretching peak | [44] |
| 1020 | Stretching of C-O-C bond | [44] |
| 1605 | Stretching absorption of benzene ring | [45] |
| 1510 | Stretching C=O of aldehyde group | [45] |
| 1431 | Phenyl ring | [46] |
| 1366 | -CH3 | [46] |
| 1266 | =C-O-C of aromatics | [46] |
Publisher’s Note: MDPI stays neutral with regard to jurisdictional claims in published maps and institutional affiliations. |
© 2022 by the authors. Licensee MDPI, Basel, Switzerland. This article is an open access article distributed under the terms and conditions of the Creative Commons Attribution (CC BY) license (https://creativecommons.org/licenses/by/4.0/).
Share and Cite
Zaineb, T.; Uzair, B.; Rizg, W.Y.; Alharbi, W.S.; Alkhalidi, H.M.; Hosny, K.M.; Khan, B.A.; Bano, A.; Alissa, M.; Jamil, N. Synthesis and Characterization of Calcium Alginate-Based Microspheres Entrapped with TiO2 Nanoparticles and Cinnamon Essential Oil Targeting Clinical Staphylococcus aureus. Pharmaceutics 2022, 14, 2764. https://doi.org/10.3390/pharmaceutics14122764
Zaineb T, Uzair B, Rizg WY, Alharbi WS, Alkhalidi HM, Hosny KM, Khan BA, Bano A, Alissa M, Jamil N. Synthesis and Characterization of Calcium Alginate-Based Microspheres Entrapped with TiO2 Nanoparticles and Cinnamon Essential Oil Targeting Clinical Staphylococcus aureus. Pharmaceutics. 2022; 14(12):2764. https://doi.org/10.3390/pharmaceutics14122764
Chicago/Turabian StyleZaineb, Tayyaba, Bushra Uzair, Waleed Y. Rizg, Waleed S. Alharbi, Hala M. Alkhalidi, Khaled M. Hosny, Barkat Ali Khan, Asma Bano, Mohammed Alissa, and Nazia Jamil. 2022. "Synthesis and Characterization of Calcium Alginate-Based Microspheres Entrapped with TiO2 Nanoparticles and Cinnamon Essential Oil Targeting Clinical Staphylococcus aureus" Pharmaceutics 14, no. 12: 2764. https://doi.org/10.3390/pharmaceutics14122764
APA StyleZaineb, T., Uzair, B., Rizg, W. Y., Alharbi, W. S., Alkhalidi, H. M., Hosny, K. M., Khan, B. A., Bano, A., Alissa, M., & Jamil, N. (2022). Synthesis and Characterization of Calcium Alginate-Based Microspheres Entrapped with TiO2 Nanoparticles and Cinnamon Essential Oil Targeting Clinical Staphylococcus aureus. Pharmaceutics, 14(12), 2764. https://doi.org/10.3390/pharmaceutics14122764

